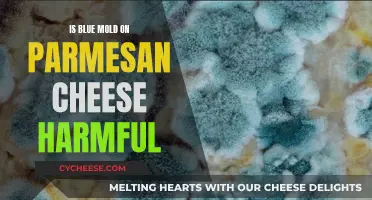
Blue Mold on Parmesan: Harmful or Harmless?

Blue Monday is a pasteurized blue cow's milk cheese created by former Blur band member Alex James. It is a sophisticated, matured, and soft blue cheese with a creamy texture and strong blue veining. The cheese has a rich, complex flavor with a subtle sweetness and intense savoriness. It is ideal when paired with dark bitter ale or stout and is often used in blue cheese sauces for steak or as a spread on bread.
| Characteristics | Values |
|---|---|
| Pasteurized | Yes |
| Type of Milk | Cow's milk |
| Texture | Semi-soft |
| Rind | Thin and natural |
| Taste | Savoury, spicy, rich, complex, sweet |
| Pairing | Dark bitter ale or stout |
| Creator | Alex James, former Blur band member |
Explore related products
What You'll Learn

Blue Monday Cheese is pasteurised
Blue Monday is a pasteurised, rich and creamy blue cheese with strong blue veining and a wonderfully soft, mellow, and creamy texture. It has a thin, natural rind with notes of herbs and minerals. The cheese has a faintly sweet, intensely savoury, spicy, and rich complex flavour. It is matured for a minimum of 12 weeks and weighs approximately 1.2kg.
Blue Monday is made by the skilled team at Shepherds Purse in Thirsk, North Yorkshire, led by Judy Bell's two daughters, Katie and Caroline. The cheese is named after the song "Blue Monday" by New Order and has won several awards, including Gold at the British Cheese Awards 2017 and Silver at the World Cheese Awards in 2019.
Blue Monday is a great addition to a burger, soup, or salad. It can also be enjoyed as a sauce for steak or with Lincolnshire Plum Bread and some quality Jersey butter. It pairs well with dark bitter ale, stout, or Guinness.
Blue Cheese: Aging for Better Taste and Texture
You may want to see also

It's made from cow's milk
Blue Monday cheese is made from pasteurized cow's milk. In fact, most blue cheeses you'll come across—whether in a supermarket or on a salad in a chain restaurant—are made with pasteurized milk. This is because, in general, cheese made from cow's milk is more likely to be pasteurized than cheese made from other types of milk, like goat's or sheep's milk.
That being said, it is possible to find blue cheese made from raw (unpasteurized) cow's milk. Raw milk is milk that has not been heated to kill bacteria, and it is usually more readily available to those who live closer to farms. If you are making blue cheese at home and know that your milk has been pasteurized, you should add Calcium Chloride to the milk to encourage better coagulation of the milk into curds and whey.
If you are buying blue cheese in a supermarket, you can check the ingredients to see if it is made from pasteurized milk. If you are buying blue cheese from a cheese counter, natural foods store, or chic restaurant, it is more likely to be unpasteurized.
It is important to note that, in the United States, certain specialty cheeses, like Grana Padano, must be made with raw milk and aged for a minimum of 60 days to comply with US regulations.
Amablu Blue Cheese: Is Pasteurization a Part of Its Process?
You may want to see also

It's a semi-soft cheese
Blue Monday is a pasteurized, semi-soft cheese. It is a blue cow's milk cheese created by former Blur band member Alex James, who stepped away from his rock 'n' roll lifestyle in 2003 to become a cheesemaker. James is passionate about cheese and is fluent on the subject. Blue Monday has a wonderfully soft, mellow, and creamy texture, with a thin natural rind. The cheese has bold cracks and blue streaks, and the rind is edible with notes of herbs and minerals. It is faintly sweet, intensely savoury, spicy, and rich, with a complex flavour.
Blue Monday is matured for a minimum of 12 weeks and is made by the very skilled team at Shepherd's Purse in Thirsk, North Yorkshire. The company started by making cheese only from sheep's milk, but they have since extended their range to include cow's milk and even water buffalo milk cheeses. Today, they are best known for their blue cheeses, Yorkshire Blue and Harrogate Blue, which won Super Gold at the World Cheese Awards and were named in the top 15 cheeses in the world!
Blue Monday is a great choice for those who enjoy a strong-flavoured cheese. It is perfect when paired with a dark bitter ale or stout, and it also makes a delicious blue cheese sauce for steak. If you're looking for something more indulgent, try it on some Lincolnshire Plum Bread with a slab of quality Jersey butter.
Blue Monday has won several awards, including Gold at the British Cheese Awards 2017 and Silver at the World Cheese Awards in 2019. So, if you're looking for a sophisticated and award-winning semi-soft cheese, Blue Monday is an excellent option.
Spotting Spoiled Blue Cheese: Signs to Look For
You may want to see also
Explore related products

It's created by Alex James
Blue Monday cheese is a pasteurised cow's milk cheese created by Alex James, a former member of the band Blur, who has since become a cheesemaker. James left his Rock 'n' Roll lifestyle behind in 2003, moving to a 200-acre farm in a small village between Chipping Norton and Stowe-on-the-Wold. Here, he converted his stone outbuildings into cheesemaking rooms. James is passionate about cheese and has become an expert in the field.
Blue Monday is a sophisticated, rich, and creamy blue cheese with strong blue veining and a wonderfully soft, mellow, and creamy texture. It has a bold, complex flavour that is faintly sweet, intensely savoury, and spicy. The cheese is matured for up to eight weeks and develops a thin natural rind. It is named after Alex James' favourite New Order song, "Blue Monday".
Blue Monday is now made by the team at Shepherds Purse in Thirsk, North Yorkshire. Led by Judy Bell, the team has grown organically over the years, starting with sheep's milk cheese and expanding to include cow's milk and water buffalo milk cheeses. They are best known for their blue cheeses, Yorkshire Blue and Harrogate Blue, which have won several awards, including Super Gold at the World Cheese Awards.
Alex James' Blue Monday has also won several awards, including Gold at the British Cheese Awards 2017 and Silver at the World Cheese Awards in 2019. It pairs well with dark bitter ale or Guinness.
Blue Cheese Curing: A Step-by-Step Guide to Perfection
You may want to see also

It's matured for at least 12 weeks
Blue Monday cheese is matured for a minimum of 12 weeks. This process allows the cheese to develop its characteristic soft, mellow, and creamy texture, with a subtle flavour profile that is faintly sweet, savoury, spicy, and rich. The cheese is created by Alex James, a former band member of Blur, who transitioned to cheesemaking in 2003. James is passionate about cheese and is based on a 200-acre farm in a small village between Chipping Norton and Stowe-on-the-Wold. Here, he converted his stone outbuildings into cheesemaking rooms, crafting his award-winning Blue Monday cheese.
Blue Monday is a pasteurised, blue cow's milk cheese. It is a semi-soft cheese with bold cracks and blue streaks, complemented by a thin, edible natural rind. The cheese's name is derived from the song "Blue Monday" by New Order, referencing the third Monday in January, which is considered the most depressing day of the year. However, upon tasting Blue Monday cheese, one might feel the opposite of depressed, as its subtle complexity and nuanced flavour can evoke a sense of gentle emotion.
The maturation process of at least 12 weeks is crucial to the development of Blue Monday's unique characteristics. During this time, the cheese gradually transforms from a fresh curd into a semi-soft, creamy delight. The maturation period allows the cheese to cultivate the desirable mould cultures that contribute to its distinctive flavour and texture. This process involves the careful monitoring of temperature and humidity levels to ensure optimal conditions for the cheese to mature evenly and develop its intended characteristics.
Blue Monday's 12-week maturation contributes to its versatility in culinary applications. Its creamy texture and subtle flavour make it an excellent choice for a variety of dishes. Blue Monday can be enjoyed on its own, as a stand-alone table cheese, or paired with complementary foods. It is often recommended to be served with dark bitter ale, stout, or Guinness to enhance the cheese's savoury notes. Additionally, Blue Monday makes a delicious blue cheese sauce for steak or can be savoured as a generous chunk on Lincolnshire Plum Bread with a dollop of quality Jersey butter.
Blue Cheese: A Real Cheese or Just a Myth?
You may want to see also
Frequently asked questions
Yes, Blue Monday Cheese is pasteurized.
Blue Monday Cheese was created by Alex James, a former band member of Blur.
Blue Monday Cheese is a blue cow's milk cheese.
Blue Monday Cheese comes as a wheel weighing approximately 1.2kg.
Blue Monday Cheese has a faintly sweet, intensely savoury, spicy, and rich complex flavour.